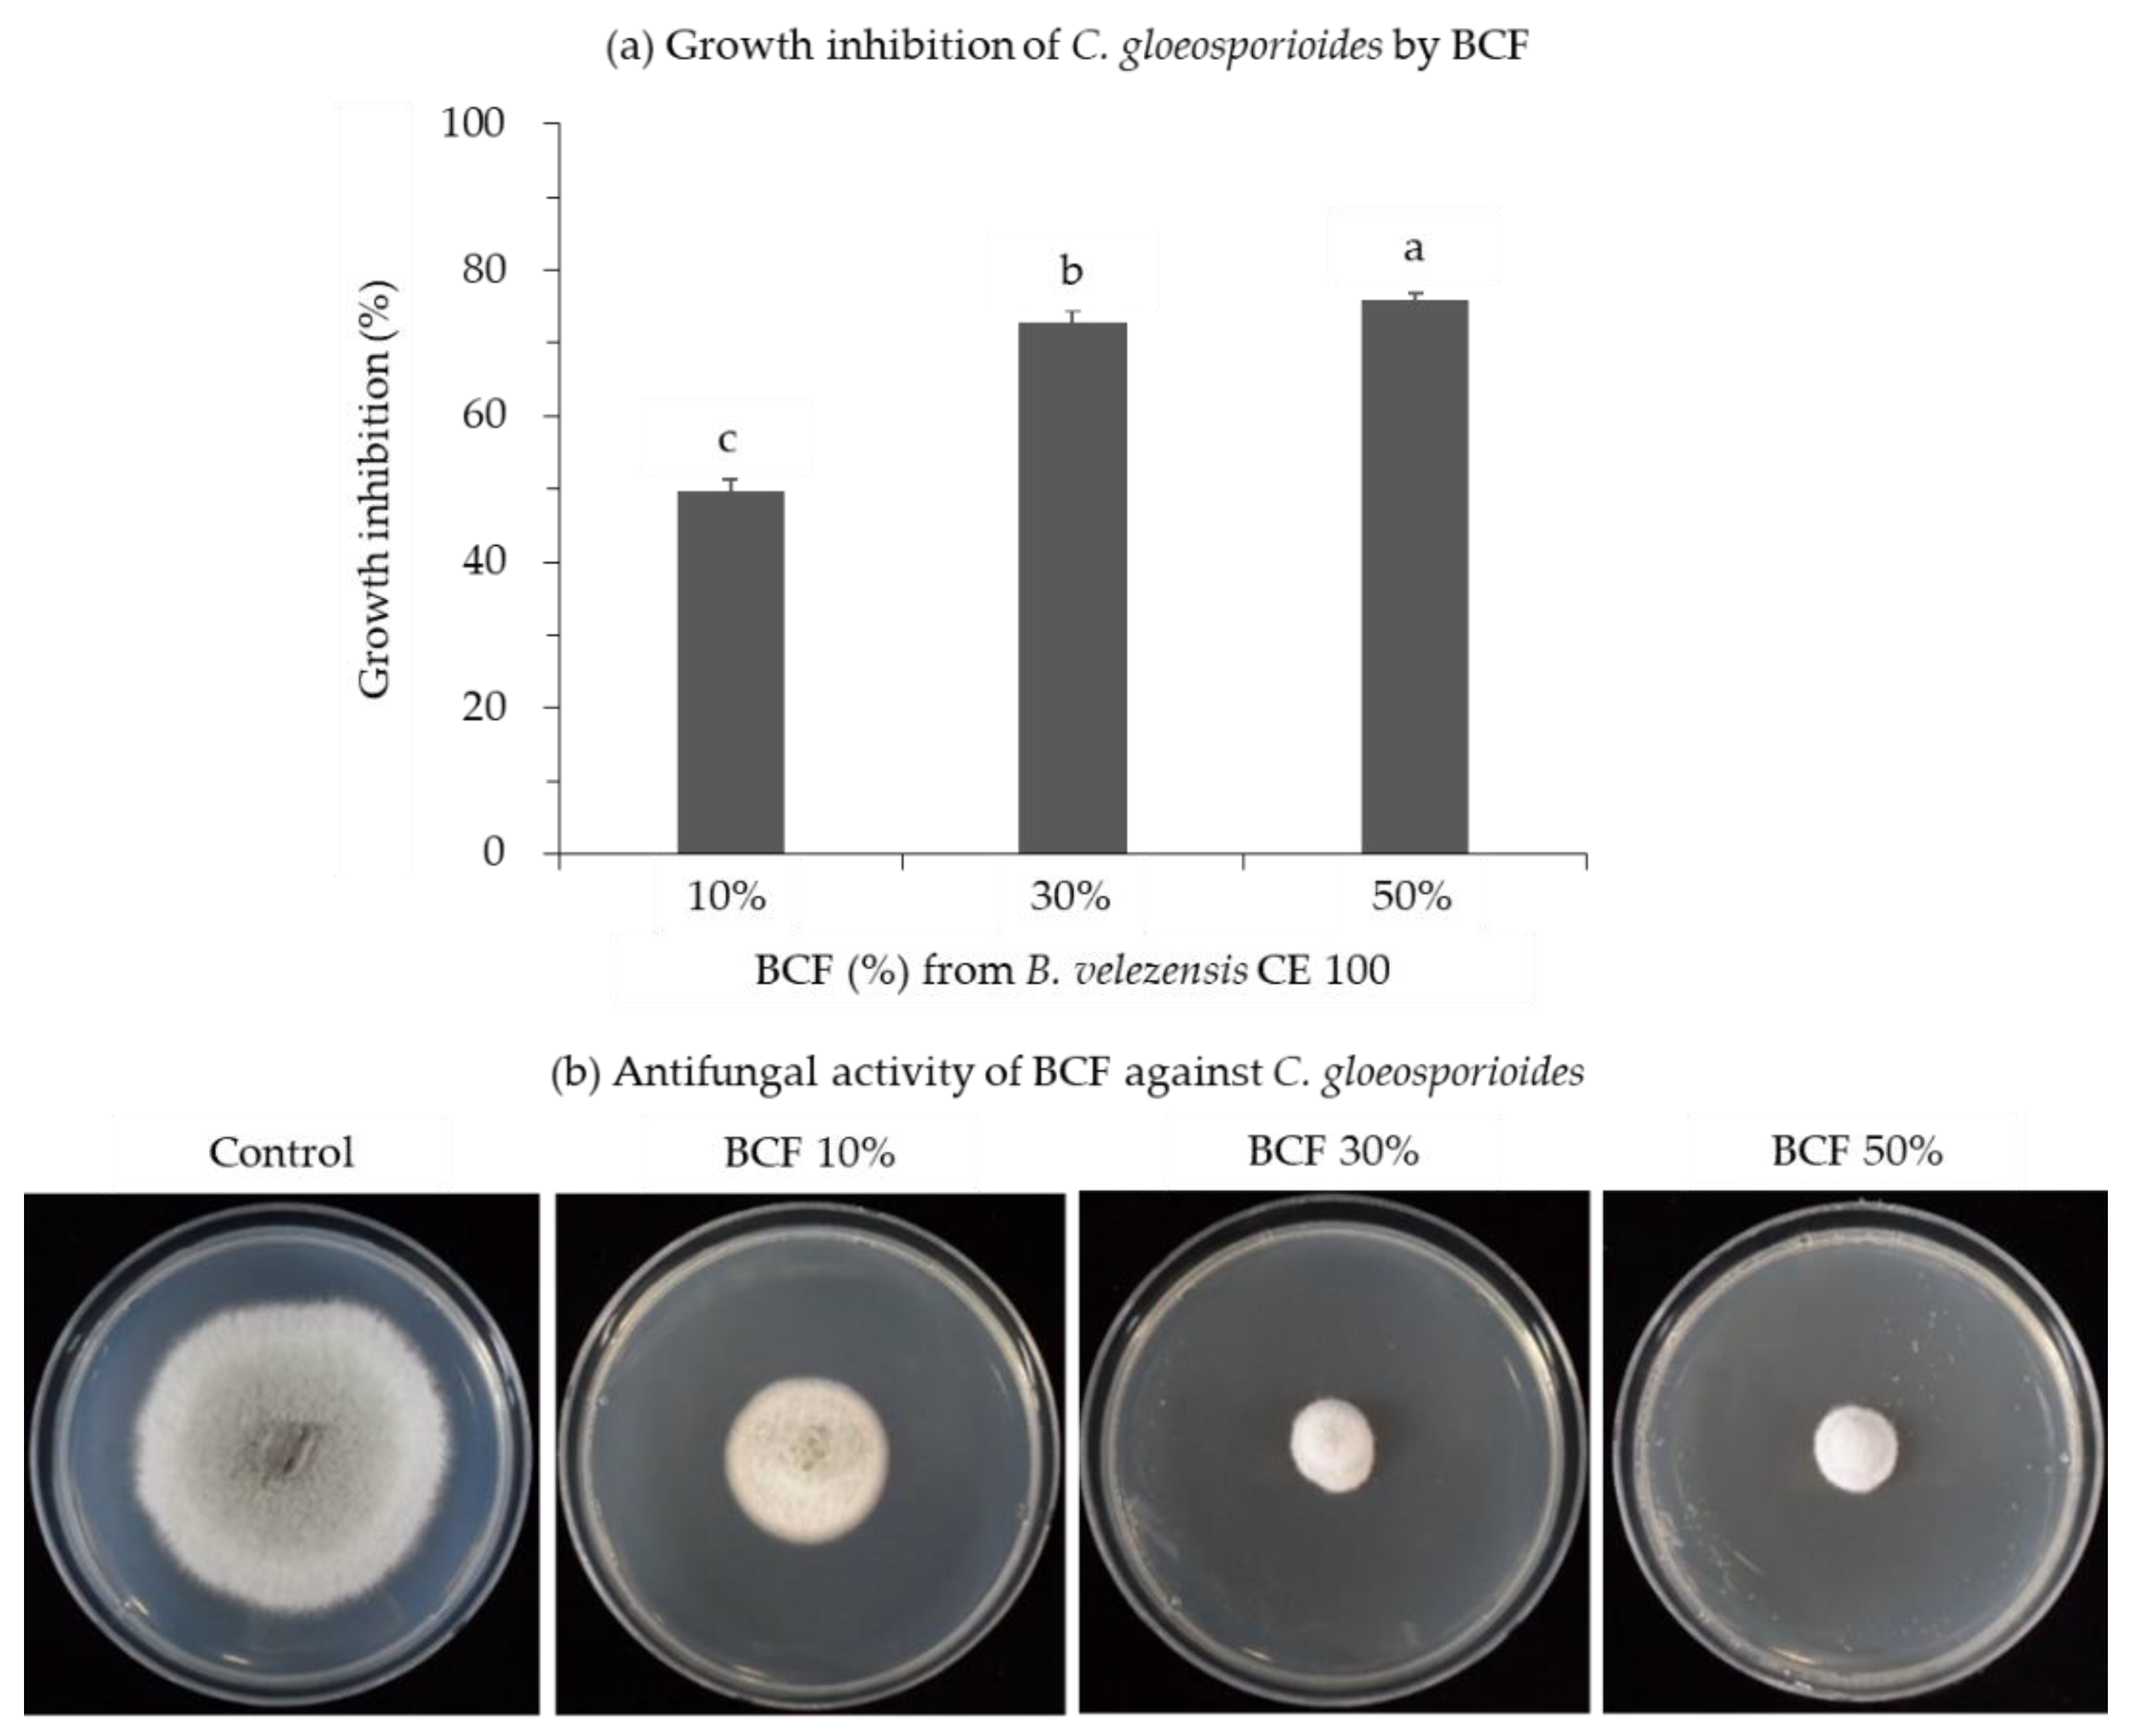
Pathogens 10 00209 g001 Pathogens 10 00209 g001

Antifungal Activity of Cyclic Tetrapeptide from Bacillus velezensis CE 100 against Plant Pathogen Colletotrichum gloeosporioides
Abstract
1. Introduction
2. Results
2.1. Antifungal Activities of B. velezensis CE 100 Culture Filtrate against Phytopathogenic Fungi
2.2. Isolation and Identification of Antifungal Cyclic Tetrapeptide
2.3. Antifungal Properties of the Cyclic Tetrapeptide against C. gloeosporioides
3. Discussion
4. Materials and Methods
4.1. Bacterial Culture and Fungal Pathogen
4.2. Antifungal Activity of B. velezensis CE 100 Culture Filtrate
4.3. Purification and Characterization of Antifungal Compound
4.4. Antifungal Properties of the Purified Compound
4.5. Statistical Analysis
Author Contributions
Funding
Institutional Review Board Statement
Informed Consent Statement
Data Availability Statement
Conflicts of Interest
References
- Savary, S.; Ficke, A.; Aubertot, J.N.; Hollier, C. Crop losses due to diseases and their implications for global food production losses and food security. J. Food Secur. 2012, 4, 519–537. [Google Scholar] [CrossRef]
- Almeida, F.; Rodrigues, M.L.; Coelho, C. The still underestimated problem of fungal diseases worldwide. Front. Microbiol. 2019, 10, 214. [Google Scholar] [CrossRef]
- Cohen, Y.; Coffey, M.D. Systemic fungicides and the control of oomycetes. Annu. Rev. Phytopathol. 1986, 24, 311–338. [Google Scholar] [CrossRef]
- Brent, K.J.; Hollomon, D.W. Fungicide Resistance: The Assessment of Risk, 2nd ed.; Fungicide Resistance Action Committee: Brussels, Belgium, 2007; pp. 1–48. [Google Scholar]
- Agrios, G.N. Plant Pathology, 3rd ed.; Academic Press Inc.: New York, NY, USA, 1988; p. 803. [Google Scholar] [CrossRef]
- Cook, R.J. Making greater use of introduced microorganisms for biological control of plant pathogens. Annu. Rev. Phytopathol. 1993, 31, 53–80. [Google Scholar] [CrossRef] [PubMed]
- Chae, D.H.; Jin, R.D.; Bo, H.J.; Kim, Y.W.; Kim, Y.C.; Park, R.D.; Krishnan, H.B.; Kim, K.Y. Control of late blight (Phytophthora capsici) in pepper plant with a compost containing multitude of chitinase–producing bacteria. BioControl 2005, 51, 339–351. [Google Scholar] [CrossRef]
- Heydari, A.; Misaghi, I.J.; Balestra, G.M. Pre-emergence herbicides influence the efficacy of fungicides in controlling cotton seedling damping-off in the field. Int. J. Agric. Res. 2007, 2, 1049–1053. [Google Scholar] [CrossRef]
- Shafi, J.; Hui, T.; Mingshan, J. Bacillus species as versatile weapons for plant pathogens: A review. Biotechnol. Biotechnol. Equip. 2017, 31, 446–459. [Google Scholar] [CrossRef]
- Baker, K.F. Evolving concepts of biological control of plant pathogens. Annu. Rev. Phytopathol. 1987, 25, 67–85. [Google Scholar] [CrossRef]
- Cook, R.J.; Bruckart, W.L.; Coulson, J.R.; Goettel, M.S.; Humber, R.A.; Lumsden, R.D.; Maddox, J.V.; McManus, M.L.; Moore, L.; Meyer, S.F.; et al. Safety of microorganisms intended for pest and plant disease control: A framework for scientific evaluation. Biol. Control 1996, 7, 333–351. [Google Scholar] [CrossRef]
- Haggag, M.; Wafaa, M.H. Sustainable agriculture management of plant diseases. Online J. Biol. Sci. 2002, 2, 280–284. [Google Scholar] [CrossRef][Green Version]
- Romanazzi, G.; Lichter, A.; Gabler, F.M.; Smilanick, J.L. Recent advances on the use of natural and safe alternatives to conventional methods to control postharvest gray mold of table grapes. Postharvest Biol. Technol. 2012, 63, 141–147. [Google Scholar] [CrossRef]
- Jeong, M.H.; Lee, Y.S.; Cho, J.Y.; Ahn, Y.S.; Moon, J.H.; Hyun, H.N.; Cha, G.S.; Kim, K.Y. Isolation and characterization of metabolites from Bacillus licheniformis MH48 with antifungal activity against plant pathogens. Microb. Pathog. 2017, 110, 645–653. [Google Scholar] [CrossRef]
- Xu, B.H.; Lu, Y.Q.; Ye, Z.W.; Zheng, Q.W.; Wei, T.; Lin, J.F.; Guo, L.Q. Genomics-guided discovery and structure identification of cyclic lipopeptides from the Bacillus siamensis JFL15. PLoS ONE 2018, 13, e0202893. [Google Scholar] [CrossRef]
- Jin, P.; Wang, H.; Tan, Z.; Xuan, Z.; Dahar, G.Y.; Li, Q.X.; Miao, W.; Liu, W. Antifungal mechanism of bacillomycin D from Bacillus velezensis HN-2 against Colletotrichum gloeosporioides Penz. Pestic. Biochem. Physiol. 2019, 163, 102–107. [Google Scholar] [CrossRef]
- Maracahipes, Á.C.; Taveira, G.B.; Sousa–Machado, L.Y.; Machado, O.; Rodrigues, R.; Carvalho, A.O.; Gomes, V.M. Characterization and antifungal activity of a plant peptide expressed in the interaction between Capsicum annuum fruits and the anthracnose fungus. Biosci. Rep. 2019, 39. [Google Scholar] [CrossRef] [PubMed]
- Won, S.J.; Choub, V.; Kwon, J.H.; Kim, D.H.; Ahn, Y.S. The Control of Fusarium Root Rot and Development of Coastal Pine (Pinus thunbergii Parl.) Seedlings in a Container Nursery by Use of Bacillus licheniformis MH48. Forests 2019, 10, 6. [Google Scholar] [CrossRef]
- Won, S.J.; Kwon, J.H.; Kim, D.H.; Ahn, Y.S. The effect of Bacillus licheniformis MH48 on control of foliar fungal diseases and growth promotion of Camellia oleifera seedlings in the coastal reclaimed land of Korea. Pathogens 2019, 8, 6. [Google Scholar] [CrossRef]
- Zhang, X.; Li, B.; Wang, Y.; Guo, Q.; Lu, X.; Li, S.; Ma, P. Lipopeptides, a novel protein, and volatile compounds contribute to the antifungal activity of the biocontrol agent Bacillus atrophaeus CAB-1. Appl. Microbiol. Biotechnol. 2013, 97, 9525–9534. [Google Scholar] [CrossRef] [PubMed]
- Cao, Y.; Pi, H.; Chandrangsu, P.; Li, Y.; Wang, Y.; Zhou, H.; Xiong, H.; Helmann, J.D.; Cai, Y. Antagonism of two plant–growth promoting Bacillus velezensis isolates against Ralstonia solanacearum and Fusarium oxysporum. Sci. Rep. 2018, 8, 4360. [Google Scholar] [CrossRef]
- Anthony, T.; Rajesh, T.; Kayalvizhi, N.; Gunasekaran, P. Influence of medium components and fermentation conditions on the production of bacteriocin(s) by Bacillus licheniformis AnBa9. Bioresour. Technol. 2009, 100, 872–877. [Google Scholar] [CrossRef]
- Chen, X.H.; Koumoutsi, A.; Scholz, R.; Schneider, K.; Vater, J.; Süssmuth, R.; Piel, J.; Borriss, R. Genome analysis of Bacillus amyloliquefaciens FZB42 reveals its potential for biocontrol of plant pathogens. J. Biotechnol. 2009, 140, 27–37. [Google Scholar] [CrossRef]
- Marcos, J.F.; Muñoz, A.; Perez-Paya, E.; Misra, S.; López-García, B. Identification and rational design of novel antimicrobial peptides for plant protection. Annu. Rev. Phytopathol. 2008, 46, 273–301. [Google Scholar] [CrossRef] [PubMed]
- Yuan, J.; Li, B.; Zhang, N.; Waseem, R.; Shen, Q.; Huang, Q. Production of bacillomycin-and macrolactin-type antibiotics by Bacillus amyloliquefaciens NJN-6 for suppressing soilborne plant pathogens. J. Agric. Food Chem. 2012, 60, 2976–2981. [Google Scholar] [CrossRef] [PubMed]
- Regente, M.C.; Giudici, A.M.; Villalaín, J.; De la Canal, L. The cytotoxic properties of a plant lipid transfer protein involve membrane permeabilization of target cells. Lett. Appl. Microbiol. 2005, 40, 183–189. [Google Scholar] [CrossRef]
- Lee, J.; Lee, D.G. Antifungal properties of the peptide derived from the signal peptide of the HIV-1 regulatory protein. Rev. FEBS Lett. 2009, 583, 1544–1547. [Google Scholar] [CrossRef] [PubMed]
- Zasloff, M. Antimicrobial peptides of multicellular organisms. Nature 2002, 415, 389–395. [Google Scholar] [CrossRef]
- Grady, E.N.; MacDonald, J.; Ho, M.T.; Weselowski, B.; McDowell, T.; Solomon, O.; Renaud, J.; Yuan, Z.C. Characterization and complete genome analysis of the surfactin-producing, plant-protecting bacterium Bacillus velezensis 9D-6. BMC Microbiol. 2019, 19, 5. [Google Scholar] [CrossRef]
- Park, G.; Nam, J.; Kim, J.; Song, J.; Kim, P.I.; Min, H.J.; Lee, C.W. Structure and mechanism of surfactin peptide from Bacillus velezensis antagonistic to fungi plant pathogens. Bull. Korean Chem. Soc. 2019, 40, 704–709. [Google Scholar] [CrossRef]
- Dean, R.; Van Kan, J.A.; Pretorius, Z.A.; Hammond-Kosack, K.E.; Di Pietro, A.; Spanu, P.D.; Rudd, J.J.; Dickman, M.; Kahmann, R.; Ellis, J.; et al. The Top 10 fungal pathogens in molecular plant pathology. Mol. Plant Pathol. 2012, 13, 414–430. [Google Scholar] [CrossRef]
- Sharma, M.; Kulshrestha, S. Colletotrichum gloeosporioides: An anthracnose causing pathogen of fruits and vegetables. Biosci. Biotech. Res. Asia 2015, 12, 1233–1246. [Google Scholar] [CrossRef]
- Baroncelli, R.; Talhinhas, P.; Pensec, F.; Sukno, S.A.; Le Floch, G.; Thon, M.R. The Colletotrichum acutatum species complex as a model system to study evolution and host specialization in plant pathogens. Front. Microbiol. 2017, 8, 2001. [Google Scholar] [CrossRef]
- Cannon, P.F.; Damm, U.; Johnston, P.R.; Weir, B.S. Colletotrichum–current status and future directions. Stud. Mycol. 2012, 73, 181–213. [Google Scholar] [CrossRef] [PubMed]
- Erpelding, J.E. Field Assessment of Anthracnose disease response for the Sorghum germplasm collection from the Mopti region. Am. J. Agri. Biol. Sci. 2010, 5, 363–369. [Google Scholar] [CrossRef]
- Vinale, F.; Sivasithamparam, K.; Ghisalberti, E.L.; Marra, R.; Woo, S.L.; Lorito, M. Trichoderma plant pathogen interactions. Soil Biol. Biochem. 2008, 40, 1–10. [Google Scholar] [CrossRef]
- Molina–Romero, D.; Baez, A.; Quintero–Hernández, V.; Castañeda–Lucio, M.; Fuentes–Ramírez, L.E.; Del Rocío Bustillos–Cristales, M.; Rodríguez–Andrade, O.; Morales–García, Y.E.; Munive, A.; Muñoz–Rojas, J. Compatible bacterial mixture, tolerant to desiccation, improves maize plant growth. PLoS ONE 2017, 12, e0187913. [Google Scholar] [CrossRef]
- Bressuire–Isoard, C.; Broussolle, V.; Carlin, F. Sporulation environment influences spore properties in Bacillus: Evidence and insights on underlying molecular and physiological mechanisms. FEMS Microbiol. Rev. 2018, 42, 614–626. [Google Scholar] [CrossRef] [PubMed]
- Wu, L.; Wu, H.J.; Qiao, J.; Gao, X.; Borriss, R. Novel routes for improving biocontrol activity of Bacillus based bioinoculants. Front. Microbiol. 2015, 6, 1395. [Google Scholar] [CrossRef] [PubMed]
- Rungprom, W.; Siwu, E.R.O.; Lambert, L.K.; Dechsakulwatana, C.; Barden, M.C.; Kokpol, U.; Blanchfield, J.T.; Kita, M.; Garson, M.J. Cyclic tetrapetides from marine bacteria associated with the seaweed Diginea sp. and the sponge Halisarca ectofibrosa. Tetrahedron 2008, 64, 3147–3152. [Google Scholar] [CrossRef]
- Napitupulu, O.I.; Sumiarsa, D.; Subroto, T.; Nurleasari; Harneti, D.; Supratman, U.; Maharani, R. Synthesis of cyclo-PLAI using a combination of solid- and solution-phase methods. Synth. Commun. 2019, 49, 308–315. [Google Scholar] [CrossRef]
- Thaniyavarn, J.; Roongsawang, N.; Kameyama, T.; Haruki, M.; Imanaka, T.; Morikawa, M.; Kanaya, S. Production and characterization of biosurfactants from Bacillus licheniformis F2.2. Biosci. Biotechnol. Biochem. 2003, 67, 1239–1244. [Google Scholar] [CrossRef]
- Souto, G.I.; Correa, O.S.; Montecchia, M.S.; Kerber, N.L.; Pucheu, N.L.; Bachur, M.; García, A.F. Genetic and functional characterization of a Bacillus sp. strain excreting surfactin and antifungal metabolites partially identified as iturinlike compounds. J. Appl. Microbiol. 2004, 97, 1247–1256. [Google Scholar] [CrossRef] [PubMed]
- Korenblum, E.; von der Weid, I.; Santos, A.L.S.; Rosado, A.S.; Sebastián, G.V.; Coutinho, C.M.; Magalhães, F.C.; Paiva, M.M.; Seldin, L. Production of antimicrobial substances by Bacillus subtilis LFE-1, B. firmus H2O-1 and B. licheniformis T6-5 isolated from an oil reservoir in Brazil. J. Appl. Microbiol. 2005, 98, 667–675. [Google Scholar] [CrossRef] [PubMed]
- Choi, T.G.; Maung, C.E.H.; Lee, D.R.; Henry, A.B.; Lee, Y.S.; Kik, K.Y. Role of bacterial antagonists of fungal pathogens, Bacillus thuringiensis KYC and Bacillus velezensis CE 100 in control of root-knot nematode, Meloidogyne incognita and subsequent growth promotion of tomato. Biocontrol. Sci. Technol. 2020, 30, 685–700. [Google Scholar] [CrossRef]

| Residue | Position | δH (Int., Multi., J in Hz) | δC |
|---|---|---|---|
| Proline | 1 | a | 172.7 |
| 2 | 4.21 (1H, t, 7.5) | 60.2 | |
| 3 | 2.31−2.35 (1H, m), 1.91−1.94 (1H, m) b | 29.7 | |
| 4 | 2.03−2.06 (1H, m), 1.91−1.94 (1H, m) b | 23.4 | |
| 5 | 3.52−3.54 (2H, m) | 46.3 | |
| Valine | 1′ | a | 167.7 |
| 2′ | 4.02−4.04 (1H, m) c | 61.7 | |
| 3′ | 2.48−2.51 (1H, m) | 30.0 | |
| 4′ | 1.10 (3H, d, 7.0) | 19.0 | |
| 5′ | 0.94 (3H, d, 6.5) | 16.8 | |
| Alanine | 1″ | a | 171.4 |
| 2″ | 4.01−4.06 (1H, m) c | 51.7 | |
| 3″ | 1.45 (3H, d, 7.0) | 21.1 | |
| Isoleucine | 1‴ | a | 169.4 |
| 2‴ | 3.91 (1H, d, 2.5) | 61.1 | |
| 3‴ | 1.93−1.96 (1H, m) | 40.4 | |
| 4‴ | 1.50−1.55 (1H, m), 1.23−1.29 (1H, m) | 25.8 | |
| 5‴ | 1.03 (3H, d, 6.0) | 15.7 | |
| 6‴ | 0.96 (3H, t, 7.5) | 12.3 |
Publisher’s Note: MDPI stays neutral with regard to jurisdictional claims in published maps and institutional affiliations. |
© 2021 by the authors. Licensee MDPI, Basel, Switzerland. This article is an open access article distributed under the terms and conditions of the Creative Commons Attribution (CC BY) license (http://creativecommons.org/licenses/by/4.0/).
Share and Cite
Choub, V.; Maung, C.E.H.; Won, S.-J.; Moon, J.-H.; Kim, K.Y.; Han, Y.S.; Cho, J.-Y.; Ahn, Y.S. Antifungal Activity of Cyclic Tetrapeptide from Bacillus velezensis CE 100 against Plant Pathogen Colletotrichum gloeosporioides. Pathogens 2021, 10, 209. https://doi.org/10.3390/pathogens10020209
Choub V, Maung CEH, Won S-J, Moon J-H, Kim KY, Han YS, Cho J-Y, Ahn YS. Antifungal Activity of Cyclic Tetrapeptide from Bacillus velezensis CE 100 against Plant Pathogen Colletotrichum gloeosporioides. Pathogens. 2021; 10(2):209. https://doi.org/10.3390/pathogens10020209
Chicago/Turabian StyleChoub, Vantha, Chaw Ei Htwe Maung, Sang-Jae Won, Jae-Hyun Moon, Kil Yong Kim, Yeon Soo Han, Jeong-Yong Cho, and Young Sang Ahn. 2021. "Antifungal Activity of Cyclic Tetrapeptide from Bacillus velezensis CE 100 against Plant Pathogen Colletotrichum gloeosporioides" Pathogens 10, no. 2: 209. https://doi.org/10.3390/pathogens10020209
APA StyleChoub, V., Maung, C. E. H., Won, S.-J., Moon, J.-H., Kim, K. Y., Han, Y. S., Cho, J.-Y., & Ahn, Y. S. (2021). Antifungal Activity of Cyclic Tetrapeptide from Bacillus velezensis CE 100 against Plant Pathogen Colletotrichum gloeosporioides. Pathogens, 10(2), 209. https://doi.org/10.3390/pathogens10020209

